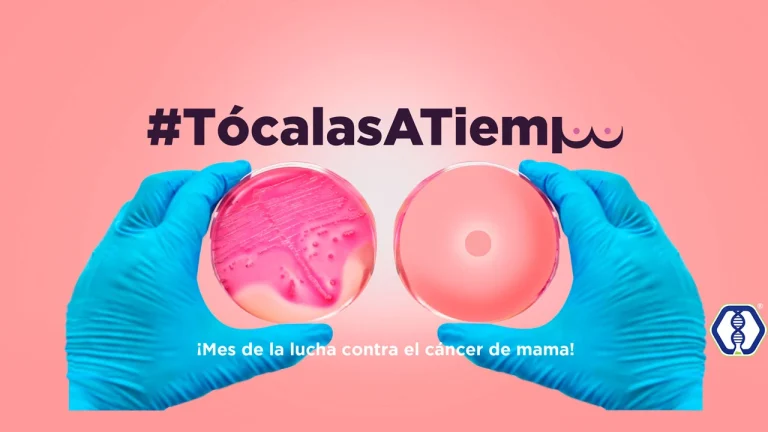

CONÓCENOS
servir con calidad es nuestra meta
Un diagnóstico
OPORTUNO
marca la diferencia
La detección y cuantificación específica de material genético, ha marcado una pauta significativa en todas las áreas de la salud. El desarrollo de nuevas tecnologías más rápidas y precisas han transformado a la Biología Molecular en una herramienta clave para el diagnóstico clínico.
Por más de 10 años de experiencia en el Diagnóstico Molecular, hemos notado que los tiempos de entrega son prolongados y los costos elevados, por lo que hacen que estas pruebas pierdan su valor. Es así como surge AL Genós, para cubrir la necesidad del paciente de conocer su resultado en el menor tiempo posible, brindando así, un servicio para su beneficio y de los que lo rodean.
NOSOTROS
BLOG
Preguntas
#AlGenosLab
El ayuno es necesario debido a que los alimentos y algunas bebidas se absorben en el torrente sanguíneo y estos pueden afectar los resultados de algunos estudios.
¡Por supuesto! No hay contradicción para ingerir agua natural, al contrario, te encontrarás hidratado y será más fácil la extracción de la sangre.
Si padeces alguna enfermedad crónica y tomas medicamento, no hay problema en que lo ingieras antes de la toma sanguínea, a menos que tu médico te indique que lo tomes después de tu prueba e incluso que pausar el medicamento y tomarlo posterior al estudio sea un requisito especial.
En cuanto se termine con el procedimiento, si deseas llevar un refrigerio para después de la extracción, no existe inconveniente alguno.
El volumen extraído no es el mismo que en una donación sanguínea, así que solo necesita desayunar adecuadamente e hidratarte.
Esto depende de cada persona, no importa el sexo, complexión o edad, influye si el o la paciente se encuentra en algún tratamiento como quimioterapia, hemodiálisis, o si padece algún problema hematológico, anemia o simplemente porque la persona sea así anatómicamente.
PCR por sus siglas en inglés significa; Reacción en Cadena de la Polimerasa, es una técnica que se utiliza en las pruebas moleculares para detectar la presencia de material genético de humanos, virus, bacterias, entre otros. Son las pruebas más recomendadas por la Organización Mundial de la Salud para realizar un diagnóstico preciso.
El único requisito es no aplicar medicamentos en la nariz o enjuagues bucales, por lo menos entre 12 y 24 horas antes de la prueba.
No, en la prueba se detecta el material genético del virus ARN, presentes en nariz y garganta.
Existen tres razones:
- Estrés emocional: miedo, ansiedad y preocupación, son los principales síntomas que pueden experimentar la mayoría de los pacientes al momento de la extracción sanguínea, por miedo a la punción e impresión al ver su propia sangre o definitivamente puede ser miedo o angustia al probable diagnostico al que se enfrentan, estas emociones repercuten en el sistema nervioso ocasionando que la presión arterial baje e incluso un desmayo.
- Hiperventilación: esta condición ocurre cuando el paciente se enfrenta al nerviosismo o ansiedad provocando acelerar la respiración, a tal grado que provoca la disminución de CO2 y ocasiona el desmayo.
- Hipoglicemia: (bajos niveles de glucosa en la sangre) provocados debido a un ayuno muy prolongado, aunque también se puede presentar en un paciente con diabetes o resistencia a la insulina, la hipoglicemia puede llegar a generar un desmayo.